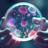
Neues Antimykotikum gegen Aspergillose

Bestrahlung gegen Aspergillus & Co.
Bislang existiert keine Vorgabe für die mikrobiologische Reinheit von Cannabisblüten. Durch Bestrahlung können Pilze, Sporen und andere Keime abgetötet werden. Bei manchen Patient:innen ist dieses Verfahren jedoch eher negativ behaftet. Zu Unrecht?
Markus Hanl, Apotheker in der Lux 99 Apotheke in Hürth, kennt sich sehr gut mit Cannabis aus. In der Offizin versorgt er gemeinsam mit seinem „Cannabis-Team“ rund 1000 Patient:innen im Monat. Von unveränderten Blüten über Extrakte bis hin zu Kapseln sind alle Arten von Cannabis-Rezepturen vertreten. Bei der Auswahl der Blüten kommt der Apotheker auch immer wieder mit dem Thema mikrobiologische Reinheit in Berührung – nicht zuletzt, weil es in der Praxis auch Negativbeispiele gibt. Ein Risiko beim natürlichen Arzneimittel ist die Schimmelbildung. Das Risiko zur Entstehung kann bereits bei der erstmaligen Abfüllung beim Hersteller vorhanden sein. Im Rahmen der diesjährigen Expopharm berichtet der Apotheker über die Möglichkeiten der Keimreduktion.
Bestrahlung – Kontrast zur „natürlichen Medizin“ ?
Aktuell sind rund 57 Prozent aller Blüten in deutschen Apotheken bestrahlt. Das Verfahren ist sowohl auf Hersteller-, als auch auf Patientenseite häufig umstritten. Während Patient:innen vor allem einen Widerspruch im Verständnis zur natürlichen Medizin sehen beziehen sich die Produzenten vor allem auf die unterschiedlichen Sichtweisen zur Notwendigkeit niedriger Keimzahlen.
„Ein aseptischer Anbau von Cannabis ist aktuell nicht möglich“, berichtet Hanl, „es können immer wieder über unterschiedlichste Wege Keime auf die Pflanze gelangen, beispielsweise über das Substrat, welches verwendet wird.“ Aus seiner Sicht ist die abschließende Bestrahlung der Blüten ein wichtiger Schritt für die Patientensicherheit. „Gesundheitsrisiken können vor allem für immunsupprimierte Patienten entstehen. Hierzu liegen auch einige Fallberichte vor.“ Besonders gefährlich seien Keime aus der Familie der Aspergillus-Pilze. „Schimmelpilze wie der Aspergillus fumigatus konnten bereits in Proben aus Vaporisern detektiert werden.“ Auch in seinem eigenen Apothekenalltag kam der Apotheker bereits mit mikrobiologisch belastetem Cannabis in Berührung.
Die Inhalation dieser Schimmelpilze kann zu schwerwiegenden Infektionen führen. Vorbelastete Patient:innen, sowie Raucher:innen können im schlimmsten Fall einen tödlichen Verlauf erfahren. Durch eine Pilz- oder Sporenbelastung, falsche Lagerung oder einem generell zu hohen Feuchtigkeitsgrad kann es zur herabgesetzten Wirksamkeit der Blüten kommen.
In der Blüte bleibt keine Reststrahlung zurück
Durch die Bestrahlung werden die Genome der Mikroorganismen durch ionisierende Strahlung geschädigt. „In anderen Ländern findet dieses Verfahren unter anderem bei Lebensmitteln Anwendung“, berichtet Hanl, „in Deutschland ist dies im Lebensmittelbereich nur für Gewürze zulässig.“ In anderen Bereichen wie der Sterilisation von Medizinprodukten ist die Gamma-Bestrahlung ein häufig eingesetztes Verfahren. „Es entstehen keine Radionuklide. Das heißt, das Produkt strahlt keinesfalls.“ Die Bedenken vieler Patient:innen könnten durch eine ausführliche Beratung aus dem Weg geräumt werden.
Unternehmen, die bestrahltes Cannabis in den Umlauf bringen wollen, benötigen eine Bestrahlungslizenz. Diese ermächtigt die Hersteller, die Blüten mit einer definierten maximalen Strahlendosis zu behandeln. Die Gamma-Bestrahlung nimmt, im Gegensatz zum Autoklavieren, keinen Einfluss auf den THC- und CBD-Gehalt. Lediglich der Gehalt der Monoterpene kann sich geringfügig verändern. Untersuchungen zeigen hier eine Reduktion um 10 bis 20 Prozent. Hanl zieht folgendes Fazit: „Der Benefit hinsichtlich der Sicherheit schwer kranker Patienten überwiegt gegenüber dem geringfügigen Verlust an Terpenen.“

APOTHEKE ADHOC Debatte